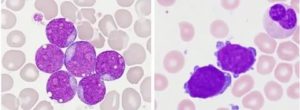

Что значат нормобласты в крови
Общий анализ крови регулярно используется медицинскими работниками с целью выявления скрытых заболеваний. Расшифровка полученных результатов осуществляется благодаря специальным таблицам с показателями рассчитанной нормы для каждого компонента биоматериала.
При наличии каких-либо патологий у пациента будет нарушено соотношение маркеров. Однако, если лейкоциты или эритроциты обязательно должны выявляться на диагностике, то бласты в крови зачастую будут свидетельствовать о нарушениях в работе иммунной системы.
Что представляют собой нормобласты?
Бластные клетки – это промежуточная форма эритроцитов (красных кровяных телец), отвечающих за насыщение тканей тела кислородом, а также выведение из организма углекислого газа.
Данные вещества формируются, как и все форменные элементы крови, в костном мозге. Иссиня-фиолетовые клетки на данном этапе развития активно обогащаются гемоглобином, который провоцирует уменьшение ядра.
Когда оно полностью растворится, нормобласты приобретут более миниатюрные размеры и преобразуются в ретикулоциты розоватого оттенка.
Бластные клетки в анализе крови под микроскопом Они, в свою очередь, покидают свою обитель, поступая непосредственно в кровоток, где на протяжении 1–3 дней избавляются от ненужных органоидов (митохондрий, эндоплазматической сети). Ретикулоциты уже могут осуществлять перенос кислорода, однако их функциональность значительно повышается после полноценного превращения в эритроциты двояковогнутой формы.
Нередко специалисты при расшифровке показателей упоминают нормоциты или бластоциты. Необходимо запомнить, что эти термины являются медицинской интерпретацией нормобластов.
Если уровень содержания бластов в крови достаточно повышен, организм может быть поражен следующими заболеваниями:
- остеосаркома;
- патология Ди Гульермо;
- острый эритролейкоз;
- миелобластная анемия;
- рак костного мозга;
- глиобластома;
- множественные метастазы;
- лимфобластный лейкоз;
- талассемия;
- гепатома;
- экстрамедуллярное кроветворение;
- мегалобластическое малокровие;
- гипопластическая анемия;
- бронхогенная карцинома.
Иногда причиной появления нормобластов в анализе крови является гемолиз – болезнь, характеризующаяся патологическим разрушением эритроцитов с выделением в кровь гемоглобина.
Когда организм человека теряет важнейших переносчиков углекислого газа и кислорода, развивается гипоксия.
Для того чтобы избежать необратимых последствий, на помощь иммунной системе костный мозг посылает нормобласты, которые временно замещают своих более зрелых «собратьев».
Нередко количество нормоцитов диагностируется у женщин после обильных менструаций или тяжелых родов, которые повлекли за собой повреждение внутренних органов. Если пациент ранее перенес инфекционное заболевание, в результатах его общего анализа крови, скорее всего, тоже обнаружатся нормоциты.
Серьезная кровопотеря, вызванная тяжелым ранением, в норме будет характеризоваться появлением нормобластов, стабилизирующих функцию кроветворения
Как проводят забор крови?
Как правило, для процедуры ОАК требуется капиллярная кровь из безымянного пальца. После того как его подушечка будет продезинфицирована медицинским спиртом, производится безболезненный прокол с помощью автоматического скарификатора. Периодически сжимая палец у ногтевой пластины, лаборант набирает около 2–3 мл биоматериала с помощью стеклянного капилляра.
Когда пробы крови будут распределены по емкостям, ранку снова дезинфицируют и накладывают на нее стерильный ватный диск. Намного реже для лабораторного исследования берут венозную кровь из локтевого сосуда. В таком случае сначала накладывают на плечо жгут и обрабатывают место пункции, после чего иглу вакуумной системы или одноразового шприца вводят в вену.

Угол наклона иглы постепенно уменьшают, облегчая забор материала. Как только процедура завершится, к области прокола прижимают марлевый тампон, выводят иглу из сосуда и снимают жгут. Придерживать ватку нужно до тех пор, пока ранка не закупорится кровяным сгустком, иначе в области сгиба образуется болезненная подкожная гематома.
Подготовка к диагностике
Анализ крови на РФМК + расшифровка
Получив результаты общего анализа, лечащий врач никогда не будет оценивать лишь один его параметр, не обращая внимания на остальные.
Для того чтобы баланс количественного содержания всех форменных элементов крови помимо нормобластов не был искусственно нарушен, следует на протяжении нескольких дней перед диагностикой придерживаться некоторых правил подготовки.
За неделю до процедуры нужно сообщить специалисту перечень принимаемых препаратов, чтобы он мог оценить степень их воздействия на состав крови. Если некоторые медикаменты вызывают нежелательные изменения, их использование временно приостанавливается. За 3–4 дня из рациона изымаются вредные продукты и напитки, особенно фастфуд, алкоголь, маринады, жирная и жареная пища.
Также необходимо на 1–2 дня прекратить спортивные занятия, бег и плавание не являются исключением. Посещать медицинское учреждение следует натощак. Курить перед диагностикой запрещается. Если пациент спешно пришел в клинику, ему обязательно нужно отдышаться, прежде чем заходить в кабинет.
Не рекомендуется накануне забора крови злоупотреблять кондитерскими изделиями – превышение дневной дозировки сладостей влечет за собой ложный результат исследования
Всегда ли повышенный уровень – признак патологии?
Вовсе нет. Например, нормобласты в общем анализе крови у абсолютно здоровых младенцев до 3–4 месяцев – вполне допустимое явление, связанное с активным физиологическим формированием маленького организма.
У детей старшего возраста бластоциты должны наблюдаться лишь в области костного мозга, а не в крови.
Если забор биоматериала осуществляется у пациента с пернициозным (злокачественным) малокровием, тогда выявление нормоцитов считается предвестником скорой ремиссии.
При подобных обстоятельствах бластные клетки будут свидетельствовать о наличии функциональности защитных механизмов. Более того, люди иногда получают неутешительные результаты, которые перечеркивались показателями повторной диагностики. Поэтому не стоит переживать, увидев тревожные цифры на бланке, нужно спокойно посетить специалиста с целью их подтверждения или опровержения.
Источник:
Диагностика бластных клеток в крови
Для того, чтобы вовремя определить есть ли у пациента онкологического заболевание обычно делается анализ крови на рак, лейкоз. Если врач обнаруживает бластные клетки в анализе крови, то это считается признаком наличия у пациента острого лейкоза в крови.
Что это такое
Бластные клетки в анализе крови, что это такое? Они представляют собой незрелые клетки, из которых затем образуются нормальные кровяные тельца. В норме в кровеносной системе они не встречаются, а находятся всегда в костном мозге, поэтому после проведения этого анализа проверяют и костный мозг на наличие нормобластов.
Нормальная кровь и при лейкозе
Разновидности лейкоза
Медицина подразделяет лейкоз крови на две разновидности – это хроническая форма лейкоза (состоит из зрелых и незрелых элементов), причём никогда не переходит в острою форму лейкоза (при ней обнаруживаются бласты в составе крови). Эти клетки при остром лейкозе являются опухолевой составляющей в организме человека.
Обычно такая форма заболевания имеет название от клеток, предшественниками которых являются незрелые бластные клетки, например, это могут быть миелобласты, лимфобласты, монобласты, эритробласты. Таким образом, выделяют острый миелобластный лейкоз, острый лимфобластный лейкоз и другие формы рака крови.

Врачи во всём мире используют определение и обозначение бластных клеток в анализе крови с помощью международной системы ФАБ, которая предусматривает характеристику острого лейкоза по степени полиморфизма, по форме ядра бластов, в зависимости от созревания бластов или без их созревания.
Определённых симптомов бластных клеток в организме, по которым можно определить наличие лейкемии в крови, не существует, но чем раньше вы почувствуете недомогание, сдадите общий анализ крови, тем быстрее специалист сможет выявить данную патологию. Следует помнить, что острая форма лейкоза крови, в большинстве случаев встречается у детей.
Особенности анализа
Для диагностики острой формы лейкоза, необходимо сдать общий анализ крови и по нему специалист определит какие заболевания есть у вас в наличии. Если количество эритроцитов понижено, то говорится о нормохромном характере анемии.
Скорее всего, при таком анализе на бластные клетки будет выявлено и пониженное количество тромбоцитов. В редких случаях их количество сильно увеличено, и они имеют ядра причудливой формы.
СОЭ (скорость оседания эритроцитов) при острой форме лейкоза повышена, но бывают случаи, когда она находится в норме.
Система автоматического анализа лейкоцитов
Следует знать, что в норме бластные клетки в анализе крови отсутствуют, так как они находятся в костном мозге и не выходят за его пределы. Первым симптомом лейкоза крови, однако, является высокий уровень лейкоцитов, которые находятся в крови вместе с бластными клетками.
В любом случае, по одному общему анализу крови, диагноз лейкемия не ставится. Если цитопения непонятна, то в обязательном порядке берётся из костного мозга исследование в виде пункции.
Бывают случаи, при которых данная процедура, что тромбоциты в норме и бластные клетки в крови отсутствуют, и при взятии из костного мозга пункции определяется, что бласты тоже в пределах нормы, но, если специалист имеет сомнения в диагнозе, то делается трепанобиопсия, которая находит в крови пролифераты клеток, по ним и определяется наличие или отсутствие заболевания.
В инвитро, бластные клетки в анализе крови определяются разными способами и проводятся повторное тестирование крови, которое поможет поставить правильный диагноз.
Проведение анализа
Анализ на бластные клетки, на рак, как всегда, сдается утром натощак и специальной подготовки к нему не требуется. Проводят забор крови из вены.
Если анализ крови на лейкемию берется с утра, то в лаборатории намного легче определяются нормобласты и другие клетки, указывающие аномальные отклонения в организме больного.
Конечно, такое исследование проводится по желанию пациента, если он начал замечать у себя плохое самочувствие и другие признаки болезни.
Однако следует помнить, что острая форма лейкоза у женщины и мужчины проходит обычно стремительно, поэтому, чем раньше была проведена диагностика, тем лучше.
Эта болезнь, в большинстве случаев, встречается у детей, поэтому выявить аномальные клетки, которые быстро распространяются в организме можно легко. Поэтому врачи советуют родителям регулярно сдавать детям такой анализ на исследование крови направлению педиатра.
Источник:
Миелограмма: нормы, повышенные и пониженные показатели
Заболевания системы кроветворения не щадят никого — ни взрослых, ни маленьких детей. Успех лечения, сохранение жизни пациентов прежде всего зависит от своевременной диагностики.
Обязательным диагностическим методом контроля состояния костного мозга является костно-мозговая пункция.
Получаемая при этом миелограмма покажет все, что происходит с органами кроветворения, поможет выявить злокачественные новообразования на ранних стадиях, назначить правильное лечение.
Что такое миелограмма?
Мазок нормального костного мозга

Миелограмма — это данные гематологического микроскопического исследования, полученные в результате пункции красного костного мозга.
Цель проведения анализа — оценка качественного и количественного состава клеток костного мозга (миелоидная ткань), содержание различных миелокариоцитов в процентах.
Клеточное содержание костного мозга является отражением кроветворной функции организма человека. В нем происходит образование, созревание (дифференцировка) клеток-предшественниц миелоидного ростка кроветворения — форменных элементов крови:
- эритроцитов,
- лейкоцитов,
- тромбоцитов.
Любое изменение со стороны гемопоэза отражается в миелограмме, по данным которой судят о наличии патологии системы крови, оцениваются типы кроветворения, динамика заболевания, назначается, корректируется получаемое лечение.
Для максимально полной оценки состояния системы кроветворения полученные данные миелограммы обязательно необходимо оценивать вместе с общим развернутым клиническим анализом периферической крови.
Нормы миелограммы
Миелограмма — картина красного костного мозга в микроскопе
В норме в образцах костного мозга допускается содержание не более 1,7% бластных клеток.
Изменение даже одного показателя миелограммы является показанием для более детального дальнейшего обследования пациентов.
Ниже приведены показатели миелограммы в норме:
| Бласты | 0,1-1,1 |
| Миелобласты | 0,2-1,7 |
| Нейтрофильные клетки: | |
| Промиелоциты | 1,0-4,1 |
| Миелоциты | 7,0-12,2 |
| Метамиелоциты | 8,0-15,0 |
| Палочкоядерные | 12,8-23,7 |
| Сегментоядерные | 13,1-24,1 |
| Все нейтрофильные элементы | 52,7-68,9 |
| Эозинофилы (всех генераций) | 0,5-5,8 |
| Базофилы | 0-0,5 |
| Эритробласты | 0,2-1,1 |
| Пронормоциты | 0,1-1,2 |
| Нормоциты: | |
| Базофильные | 1,4-4,6 |
| Полихроматофильные | 8,9-16,9 |
| Оксифильные | 0,8-5,6 |
| Все эритроидные элементы | 14,5-26,5 |
| Лимфоциты | 4,3-13,7 |
| Моноциты | 0,7-3,1 |
| Плазматические клетки | 0,1-1,8 |
| Кол-во мегакариоцитов (клеток в 1 мкл) | 50-150 |
| Кол-во миелокариоцитов (в тыс. в 1 мкл) | 41,6-195,0 |
| Лейко-эритробластическое соотношение | 4(3):1 |
| Костно-мозговой индекс созревания нейтрофилов | 0,6-0,8 |
Повышенный показатель
Преобладание эритроцитов — признак миелоидного лейкоза
В зависимости от того, какие показатели миелограммы повышены, будет идти речь о каком-либо заболевании крови.
Если в костном мозге отмечается увеличение количества мегакариоцитов, это говорит о наличии метастазов в костях. В случае увеличения бластов на 20% и более речь идет об остром лейкозе.
Повышенное соотношение эритроциты/лейкоциты свидетельствует о миелозе, хроническом миелолейкозе, миелозе сублейкемического характера.
Индекс созревания нейтрофилов — маркер бластного криза, хронического миелолейкоза.
Рост эритробластов присущ острому эритромиелозу, анемиям. Повышение количества моноцитов наблюдается при хронических миелолейкозах, лейкозах, генерализованных инфекциях. Повышение концентрации плазматических клеток указывает на агранулоцитоз, миеломную болезнь, анемии апластического генеза.
Увеличение эозинофилов в миелограмме говорит о выраженных аллергических реакциях, онкологических заболеваниях различной локализации, лимфогранулематозе, острых лейкозах.
При каждом из обнаруженных изменений необходима дальнейшая диагностика с целью скорейшего начала противоопухолевой терапии и стабилизации состояния пациентов.
Повышение в пунктате костного мозга базофилов может свидетельствовать о миелолейкозе, эритремии, лейкозе базофильного характера. Лимфоцитоз определяется в случае хронических лимфолейкозов, апластической анемии.
Пониженный показатель
Угнетающее влияние на кроветворение могут оказывать цитостатики
Обнаружение снижения синтетической функции костного мозга также свидетельствует о заболеваниях системы кроветворения или является следствием противоопухолевой терапии.
При понижении мегакариоцитов предполагаются аутоиммунные нарушения гипопластического или апластического генеза. Часто такое явление диагностируется на фоне приема цитостатических лекарственных препаратов, радиотерапии.
Снижение данных роста эритроцитарного и лейкоцитарного ростков кроветворения указывает на эритремию, гемолиз, состояния после профузных кровотечений, острый эритромиелоз.
Анемия, вызванная недостатком В12, будет характеризоваться понижением индекса эритробластной дифференцировки. Снижение же количества эритробластов непосредственно характерно для аплазии костного мозга, апластической анемии, статуса после химиотерапевтического и радиологического лечения онкологических больных.
Снижение нейтрофильных миелоцитов, метамиелоцитов, сегментоядерных и палочкоядерных нейтрофилов наблюдается при иммунном агранулоцитозе, анемия апластического генеза, после лечения цитостатическими препаратами.
Показания и противопоказания к проведению
Проведение процедуры имеет показания и противопоказания
Взятие пунктата костного мозга осуществляется по абсолютным или относительным показания.
Обязательно проведение пункции при следующих состояниях:
- любые анемии (кроме анемии, обусловленной недостатком железа);
- понижение клеточного состава любого ростка кроветворения, обнаруживаемые в общем анализе крови;
- лейкозы острые;
- манифестация хронических лейкозов для уточнения диагноза и исключения/подтверждения наличия лейкемоидных реакций;
- одиночное повышение скорости оседания эритроцитов без наличия каких-либо инфекционно-воспалительных заболеваний. В данном случае миелограмма нужна для исключения макроглобулинемии Вальденстрема, множественной миеломы;
- подтверждение/исключение костно-мозговых метастазов;
- лимфогранулематозы;
- неходжкинские лимфомы;
- увеличение селезенки невыясненной этиологии;
- определение тканевой совместимости при операциях по пересадке костного мозга.
К относительным показаниям относят:
- анемии вследствие нехватки железа;
- хронические лейкозы.
Не показано исследование лицам с острой патологией сердечно-сосудистой системы, острой недостаточностью мозгового кровообращения, в периоды обострений патологии сердца, бронхиальной астмы.
Как происходит взятие образца
Проведение стернальной пункции
Процедура занимает 10-15 минут и проводится в стерильных условиях под местной анестезией.
Для этого больного укладывают на кушетку, область прокола обрабатывается антисептическими растворами, а обезболивающее средство вводится подкожно и в надкостницу.
После этого иглой с полым каналом внутри производится прокол по середине грудины на уровне третьей пары ребер. В полость шприца полой иглой набирается приблизительно 0,3 мл пунктата костного мозга, на место прокола накладывается стерильная повязка.
Из полученного образца, ввиду быстрого свертывания крови, сразу же готовится мазок и проводится исследование. Ориентировочное время подсчета миелограммы составляет 4 часа.
Проведение пункции детям младше 2 лет проводится из большеберцовой кости или пяточной кости, детям более старшего возраста — из гребня подвздошной кости, у взрослых образцы берутся не только из грудины, но и из подвздошной кости.
Расшифровка результатов миелограммы
В расшифровке миелограммы помогает следование алгоритму
Для аналитики результатов каждой пункции существует алгоритм, с помощью которого миелограмма полностью отражает картину кроветворения пациентов.

Для этого при описании миелограммы обязательно включаются в описание гемопоэтических характеристик:
- клеточность полученного содержимого;
- состав клеток;
- тип кроветворения;
- очаги атипичных клеток и/или их конгломератов;
- значение индекса соотношения красные/белые кровяные тельца;
- индексы дифференциации нейтрофилов, эритрокариоцитов.
Особую важность составляет отсутствие крови в полученном пунктате. При наличии крови миелограмма будет некорректна, а исследование необходимо будет повторить.
Возможные осложнения
Качественный забор пунктата — минимальный риск осложнений
При неправильной технике забора биологического материала возможны следующие осложнения:
- кровотечение,
- сквозные проколы кости,
- присоединение инфекции в области прокола,
- перелом грудины.
Во избежание развития осложнений необходимо придерживаться рекомендаций врача и тщательно выбирать место проведения пункции костного мозга.
Источник:
Бластные клетки в анализе крови: что это такое, норма, обозначение, определение, инвитро
Бластные клетки – это промежуточная форма эритроцитов (красных кровяных телец), отвечающих за насыщение тканей тела кислородом, а также выведение из организма углекислого газа.
Данные вещества формируются, как и все форменные элементы крови, в костном мозге. Иссиня-фиолетовые клетки на данном этапе развития активно обогащаются гемоглобином, который провоцирует уменьшение ядра.
Когда оно полностью растворится, нормобласты приобретут более миниатюрные размеры и преобразуются в ретикулоциты розоватого оттенка.
Бластные клетки в анализе крови под микроскопом
Они, в свою очередь, покидают свою обитель, поступая непосредственно в кровоток, где на протяжении 1–3 дней избавляются от ненужных органоидов (митохондрий, эндоплазматической сети). Ретикулоциты уже могут осуществлять перенос кислорода, однако их функциональность значительно повышается после полноценного превращения в эритроциты двояковогнутой формы.
Нередко специалисты при расшифровке показателей упоминают нормоциты или бластоциты. Необходимо запомнить, что эти термины являются медицинской интерпретацией нормобластов.
Если уровень содержания бластов в крови достаточно повышен, организм может быть поражен следующими заболеваниями:
- остеосаркома;
- патология Ди Гульермо;
- острый эритролейкоз;
- миелобластная анемия;
- рак костного мозга;
- глиобластома;
- множественные метастазы;
- лимфобластный лейкоз;
- талассемия;
- гепатома;
- экстрамедуллярное кроветворение;
- мегалобластическое малокровие;
- гипопластическая анемия;
- бронхогенная карцинома.
Иногда причиной появления нормобластов в анализе крови является гемолиз – болезнь, характеризующаяся патологическим разрушением эритроцитов с выделением в кровь гемоглобина.
Когда организм человека теряет важнейших переносчиков углекислого газа и кислорода, развивается гипоксия.
Для того чтобы избежать необратимых последствий, на помощь иммунной системе костный мозг посылает нормобласты, которые временно замещают своих более зрелых «собратьев».
Нередко количество нормоцитов диагностируется у женщин после обильных менструаций или тяжелых родов, которые повлекли за собой повреждение внутренних органов. Если пациент ранее перенес инфекционное заболевание, в результатах его общего анализа крови, скорее всего, тоже обнаружатся нормоциты.
Серьезная кровопотеря, вызванная тяжелым ранением, в норме будет характеризоваться появлением нормобластов, стабилизирующих функцию кроветворения
Нормы бластных клеток в анализе крови, диагностика и расшифровка результатов
Анализ крови на РФМК расшифровка
Получив результаты общего анализа, лечащий врач никогда не будет оценивать лишь один его параметр, не обращая внимания на остальные.
Для того чтобы баланс количественного содержания всех форменных элементов крови помимо нормобластов не был искусственно нарушен, следует на протяжении нескольких дней перед диагностикой придерживаться некоторых правил подготовки.
За неделю до процедуры нужно сообщить специалисту перечень принимаемых препаратов, чтобы он мог оценить степень их воздействия на состав крови. Если некоторые медикаменты вызывают нежелательные изменения, их использование временно приостанавливается. За 3–4 дня из рациона изымаются вредные продукты и напитки, особенно фастфуд, алкоголь, маринады, жирная и жареная пища.
Также необходимо на 1–2 дня прекратить спортивные занятия, бег и плавание не являются исключением. Посещать медицинское учреждение следует натощак. Курить перед диагностикой запрещается. Если пациент спешно пришел в клинику, ему обязательно нужно отдышаться, прежде чем заходить в кабинет.
Не рекомендуется накануне забора крови злоупотреблять кондитерскими изделиями – превышение дневной дозировки сладостей влечет за собой ложный результат исследования

Анализ крови – главное и первое исследование, которое назначают врачи при поступлении пациента в больницу. Он полно, быстро и дешево выдает объем информации о состоянии больного. Однако такие анализы различны, один из вариантов – исследование на количество бластных телец. Что это, зачем они нужны и какой нормальный уровень в крови? Разберемся!
Определение клеток под микроскопом
Кровь – важнейшая жидкость в организме человека. Выполняет множество функций,: от питания до защиты органов от инфекций и бактерий. За каждую «задачу» отвечают клетки крови, например: эритроциты – красные кровяные тельца, доставляют кислород в уголки человеческого тела.
Предшественниками элементов крови являются бласты. Развиваются в спинном мозге и по мере необходимости превращаются в эритроциты, лейкоциты и так далее. Здоровые тельца готовы «преобразиться» во время острых кризисов в больших количествах, появляясь в крови в виде защитных или других клеток.
Острый лейкоз – следствие нарушения в работе кроветворения на сначальных стадиях. В нормальном состоянии бластные клетки превращаются в функциональные клетки крови и выполняют свою миссию. Каждое такое тельце сразу после «появления на свет» имеет свою линию развития. Например: для эритроцитов «производятся» один вид таких клеток, а для лейкоцитов – другой и так далее.
Когда кроветворная система дает сбой, и создание здоровых базовых клеток нарушается, тельца ведут себя по-другому.
Резко снижается количество полезных клеток, падает гемоглобин, тромбоциты и лейкоциты.
Эти клетки могут быть нормальными и злокачественными. Нормальные всегда имеются в костном мозге, правда, их там очень мало, количество не превышает 5 процентов.
А вот при лейкозах в разных формах их число настолько повышается, что они могут попадать не только во всевозможные органы и ткани (особенно в почки, головной мозг, селезенку, лимфатический узлы и печень), но также порой оказаться замеченными и в крови.
В редких случаях появляются они в жидкости после аплазии. Ведь в этот период костный мозг изо всех сил восстанавливает свою работу. Но в основном это не злокачественные бласты, и появляются они в количестве не более двух процентов.
При любых других условиях не должны содержаться у здорового человека бласты в крови, норма их должна составлять ноль.
Причины
Как правило, причиной такого изменения анализа становится опасное заболевание — острый лейкоз. Если бластная клетка здорова, то со временем она вырастает в какую-либо полезную для организма клетку. И в кровь бласта при нормальных условиях никогда не попадет, оставаясь в костном мозге.
Только если пациенту вдруг необходимо много каких-то клеток при определенном заболевании, например, при тяжелой инфекции — лейкоцитов. В этом случае организм может начать активнее вырабатывать обсуждаемые клетки. Но все же их число все равно не может превысить 10 процентов, если у пациента нет никакого серьезного заболевания.
А вот бласты, которые начинают появляться в организме при остром лейкозе, совершенно иные.
Лейкозные бласты в итоге даже начинают «выгонять» здоровые нормальные клетки из их мест обитания и поселяются вместо них сами. Из-за этого появляются серьезные проблемы. Быстро идут на спад лейкоциты, гемоглобин и тромбоциты.
Пациент начинает ощущать неприятные симптомы в виде повышения температуры тела и появления слабости во всем теле.
Что касается постановки диагноза и выбора терапии для пациента, то доверять в этом случае можно только грамотному опытному специалисту.
После того, как с помощью анализа он точно выяснит, что бласты в крови увеличились и причину этого изменения — далее сможет выбрать комплексное лечение, которое окажется подходящим для пациента — наиболее эффективным и безопасным.
А вот самолечение в данном случае категорически противопоказано. Особенно рецепты народной медицины, которыми на сегодняшний день заполнен интернет. Такое лечение может значительно ухудшить самочувствие пациента и здоровье в целом.
Узнаем, что такое бласты в крови
Кровь — важнейшая трофическая ткань человеческого организма, которая обеспечивает все органы и ткани необходимыми питательными веществами, кислородом, служит буферным раствором , выполняет защитную и терморегуляционную функцию. У здорового человека кровь имеет постоянный состав , а малейшие изменения состава крови являются верным свидетельством заболевания. Кровь состоит из форменных элементов и плазмы (жидкого межклеточного вещества).
В норме все форменные элементы крови зрелые. Процесс их созревание происходит в кроветворных органах: в красном костном мозге, селезенке, лимфоузлах и вилочковой железе. Сырьем для форменных элементов крови выступают так называемые бластные клетки, или нормобласты. Эти образования не должны попадать в кровяное русло, оставаясь в тканях красного костного мозга.

Являясь недозрелыми форменными элементами крови, нормобласты не способны в полной мере выполнять все функции, характерные для форменных элементов. Например, недозревшие эритроциты еще не лишились ядра , поэтому в их составе меньшего гемоглобина, чем у зрелого эритроцита.
Такая клетка может переносить меньше кислорода и углекислого газа.
Бласты — это… Определение, понятие, норма и патология, расшифровка анализов
При подозрении на лейкоз врачи назначат анализ крови на бласты. Это исследование помогает своевременно выявить опасное заболевание и приступить к лечению как можно раньше. Как правильно подготовиться к взятию пробы? И как расшифровать результаты анализа? Эти вопросы мы рассмотрим в статье.
Что это такое?
Бласты представляют собой незрелые кровяные клетки, которые продуцируются в костном мозге. В дальнейшем они преобразуются в эритроциты, лейкоциты и тромбоциты. Бластные клетки являются предшественниками зрелых кровяных телец.
У здорового человека бласты в костном мозге составляют не более 5 % клеток. При инфекционных заболеваниях их концентрация может возрастать до 10 %. Однако в норме незрелые клетки не должны попадать в кровоток. Они могут находиться только в пределах костного мозга.
При тяжелых гематологических патологиях у пациента появляются бласты в крови. Что это значит? Такой результат анализа указывает на онкологические болезни системы кроветворения. При этих патологиях в костном мозге образуется чрезмерное количество незрелых элементов. Избыток бластов выбрасывается в кровоток. Их наличие в анализе является тревожным признаком.
В начальной стадии рака крови в костном мозге может находиться около 40 % бластных клеток. В дальнейшем из этих незрелых элементов образуется злокачественная опухоль.
Анализ крови
Как выявить присутствие в кровотоке бластов? Это можно сделать с помощью общего анализа крови. Это исследование показывает количество зрелых и незрелых клеток.
Для пробы берут кровь из пальца или из вены. Биоматериал изучают под световым микроскопом. Это устройство имеет специальную сетку для подсчета кровяных клеток. С ее помощью и определяют концентрацию бластов. В расшифровке анализа количество незрелых клеток указывается в процентах.
В каких случаях врачи назначают анализ на бласты? Это исследование показано, если у пациента отмечаются следующие симптомы:
- увеличение лимфатических узлов;
- беспричинное повышение температуры;
- увеличение печени и селезенки;
- слабость;
- воспаление миндалин в тяжелой форме;
- красные точки на коже;
- повышенная кровоточивость.
Очень часто пациенты принимают эти проявления за признаки ангины и других инфекционных болезней. Однако такие симптомы могут свидетельствовать о наличии тяжелой патологии костного мозга. С целью дифференциальной диагностики врачи назначают анализ на наличие бластов в крови.
Подготовка к анализу
Пробу на бластные клетки обычно берут утром, натощак. Результаты анализа чаще всего бывают готовы уже на следующий день.
Какие правила нужно соблюдать перед взятием биоматериала на бласты? Это исследование не требует сложной подготовки. Нужно придерживаться следующих рекомендаций:
- прекратить прием еды за 8 часов до теста;
- не употреблять алкоголь накануне исследования;
- за 2 часа до взятия крови исключить курение.
Рекомендуется также прекратить прием лекарств за 3 дня до анализа. Если же больной не может прервать курс медикаментозного лечения, то нужно рассказать врачу обо всех принимаемых препаратах.
Расшифровка
В норме бласты должны отсутствовать в анализе. В этом случае в результатах исследования указано, что их показатель равен 0 %. У здорового человека в крови могут находиться только зрелые элементы.
Если в анализе присутствует даже малый процент бластов, то это является опасным признаком. Результаты пробы нужно обязательно показать врачу и немедленно приступить к лечению.
Причина отклонений: лейкоз
Основной причиной появления в пробе бластных клеток является лейкоз. Это заболевание иначе называется лейкемией или раком крови. Патология сопровождается неконтролируемым делением незрелых клеток в костном мозге, которые в дальнейшем образуют опухоль.
Врачи выделяют две формы лейкоза:
При острой лейкемии в крови обнаруживается огромное количество бластных клеток. Их концентрация может быть более 20 %. При хронической форме рака крови показатель незрелых элементов обычно не превышает 5-10 %.
Другие показатели крови
При изучении результатов анализа врач обязательно обращает внимание и на другие показатели клинического исследования. Наличие бластных клеток в биоматериале всегда рассматривается в сочетании с другими параметрами крови. На наличие лейкоза могут указывать следующие данные:
- Лейкоцитоз. Примерно у 15 % больных острой формой лейкемии показатель белых кровяных телец превышает норму в десятки раз.
- Низкий гемоглобин. У пациентов с раком крови отмечается тяжелая анемия и снижение числа эритроцитов.
- Падение уровня тромбоцитов. По этой причине у больных лейкемией отмечается повышенная кровоточивость.
- Снижение ретикулоцитов. Эти клетки являются молодыми формами эритроцитов. Их малое количество приводит к анемии.
- Полное отсутствие эозинофилов и базофилов. Это становится причиной резкого снижения иммунитета.
Вышеперечисленные признаки вместе с появлением бластных клеток в крови позволяют врачу поставить диагноз «лейкоз».
Исследование костного мозга
Если у пациента в крови обнаружены бласты, то врачи обычно назначают пункцию костного мозга. Исследование проводят под местным обезболиванием. Специальной длинной иглой делают прокол в области грудины или позвоночника и берут на исследование кусочек ткани костного мозга.
Пунктат исследуют при помощи микроскопа. В биоматериале определяют количество зрелых и незрелых элементов крови. Повышение бластных клеток до 10 % не всегда указывает на лейкемию.
Такой результат исследования возможен при сильном стрессе или инфекционном заболевании. Если же концентрация бластов превышает 30 %, то это чаще всего является признаком рака крови.
При этом у больного уменьшается количество эритроцитов, тромбоцитов и лейкоцитов в пункционном материале.
При подозрении на лейкоз также проводят цитохимический анализ пунктата. Он позволяет выявить уровень ферментов бластных клеток. Эти вещества вступают в реакцию с некоторыми красителями, что и используется при лабораторном исследовании. Положительные результаты пробы указывают на лейкоз. С помощью измерения уровня каждого бластного фермента можно определить форму рака крови.
Лечение
Что делать, если анализ крови показал наличие бластных клеток? В этих случаях врач обычно назначает ряд дополнительных анализов. Самым информативным из них является пункция костного мозга. Чрезмерно высокое количество бластов в пунктате является признаком лейкемии.
Если диагноз «лейкоз» подтвердился, то необходимо немедленно приступать к лечению. Важно помнить, что на ранних стадиях рака крови вполне возможно достичь полной или частичной ремиссии. В наши дни применяются следующие методы лечения лейкемии:
- Химиотерапия. Пациенту назначают цитостатики, которые подавляют рост новообразования в костном мозге. Такое лечение может занимать довольно длительное время.
- Переливание крови. Пациенту вводят внутривенно эритроциты и тромбоциты, полученные от донора. Это помогает поднять уровень гемоглобина и уменьшить кровоточивость.
- Радиотерапия. Такой вид лечения показан при хроническом лейкозе. Пациенту облучают увеличенные лимфоузлы и область селезенки.
- Антибактериальная терапия. Пациенты с лейкозом очень подвержены инфекционным патологиям. С целью предотвращения таких заболеваний назначают курсы приема антибиотиков.
- Пересадка костного мозга. Такая операция помогает полностью избавиться от лейкоза. Сложность трансплантации заключается в том, что чужой орган кроветворения не всегда приживается.
После комплексной терапии проводят повторную пункцию костного мозга. Если концентрация бластов снизилась до 5 %, то врачи говорят о полной ремиссии.
Если же показатель незрелых клеток не превышает 20 %, то ремиссия считается частичной. В любом случае пациенту необходимо пожизненно соблюдать рекомендации врача. Лейкоз относится к опасным и тяжелым заболеваниям.
Даже при полной ремиссии нельзя исключать рецидивы патологии.
Источник: